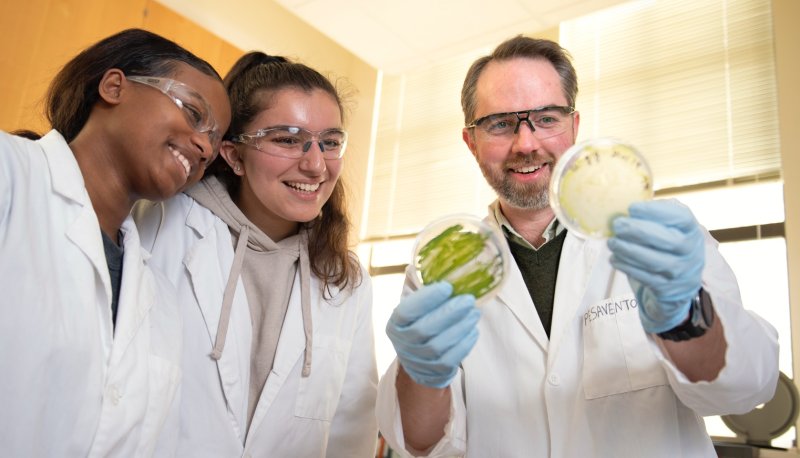
Jim Pesavento examining algae with students

Enrollment in the nursing program will be open to both current Saint Mary’s students as well as transferring and prospective students. / Photo by Steve Babuljak
Saint Mary’s Is Launching a New Bachelor of Science in Nursing Program in Fall 2025
Providing an education that transcends the classroom, empowering nurses ready to make a lasting impact in their communities—and the world.
Saint Mary’s College of California is poised to launch a new Bachelor of Science in Nursing Program beginning in fall 2025. With a curriculum and approach that honors Saint Mary’s Lasallian and liberal arts traditions, this undergraduate Registered Nursing program will deliver a holistic and compassionate educational experience.
The program is located in the Saint Mary’s School of Science and will span five semesters, including summer sessions, and offer admissions twice a year—in both fall and spring. Enrollment will be open to both current Saint Mary’s students as well as transferring and prospective students.
Saint Mary’s is in the final stages of accreditation review with the California Board of Registered Nursing (BRN) as well as the Western Association of Schools and Colleges (WASC) Senior College & University Commission (WSCUC). Once approved, the program will offer numerous pathways, including a four-year track for students beginning their undergraduate education. There is also a two-year pathway for students who transfer to Saint Mary’s to complete their bachelor’s degree.
Compassionate Nursing Professionals and Innovative Leaders

“This program is uniquely designed to prepare nurses who are both compassionate professionals and innovative leaders,” explains Dr. Pamela Stanley, who serves as the director of the nursing program. “What sets this program apart is its emphasis on preparing students for the global stage, combining theoretical foundations with practical, role-driven practice.”
The program integrates an approach pioneered by nursing theorist and researcher Dr. Maria O’Rourke, who advocates for “Role Clarity” and leverages a holistic framework centered on the principle of “Do No Harm.” In essence, the underpinnings of this program foster role accountability and empowered leadership. Students graduate as skilled clinicians equipped with the knowledge and confidence to excel in complex, dynamic healthcare environments while serving diverse populations.
And those diverse populations are only growing. So is the demand for nurses who have at least a bachelor’s degree. A recent health survey in California found the majority of hospitals prefer to hire nurses with a bachelor’s degree; and an increasing number of hospitals require that level of training. California is also one of the states projected to have the greatest need for professional nurses in the coming years.
“We’re thrilled to be offering this opportunity to students at Saint Mary’s,” says Carol Ann Gittens, who serves as Acting Senior Vice President for Academic Affairs and Provost. “The launch of the nursing program at Saint Mary’s College of California is more than an academic milestone—it is a commitment to serving our community with compassion, skill, and dedication. This program reflects our core values of social justice, service, and respect for the dignity of all. By educating the next generation of nurses, we are investing in the health and well-being of those around us, strengthening the very heart of our community.”
Building on a Legacy of Nursing Education at SMC
Equipping compassionate, capable health professionals has long been central to Saint Mary’s mission. In fact, for decades, Saint Mary’s offered a Bachelor of Science in Nursing degree through a partnership with nearby Samuel Merritt University.
The Intercollegiate Nursing Program (ICNP) was first launched in 1981. Students in the program completed two years of prerequisites and general education at Saint Mary’s, finishing their final two years of nursing courses at Samuel Merritt in Oakland. The ICNP was overwhelmingly popular; at its height, more than 350 students were enrolled.
“What sets this program apart is its emphasis on preparing students for the global stage, combining theoretical foundations with practical, role-driven practice.”
—Dr. Pamela Stanley, Director of Nursing
SMC and Samuel Merritt continued to offer a joint nursing program until the 2013–14 academic year. Today, hundreds of Saint Mary’s–educated nurses are working in hospitals and clinics worldwide. “Current Saint Mary’s students may not realize the legacy of nursing at Saint Mary’s,” says Pamela Stanley. “With this new program, we intend to build on that tradition, while also expanding and deepening it.”
In recent years, SMC has launched numerous undergraduate and graduate programs—from Computer Science to Biotechnology to Forensic Psychology—to meet the needs of the moment. The Health Science major in the School of Science also draws students interested in pursuing a career in healthcare.
Stanley, who holds a degree in Doctor of Nursing Practice as well as a master’s in nursing and an MBA, has worked with colleagues at SMC over the last several years to lay the groundwork for the nursing program. She sees it as continuing the momentum at the College to offer new and timely opportunities.
“Saint Mary’s produces disciplined thinkers committed to meaningful action,” Stanley says. “Those are exactly the kind of nurses we need right now.”
Hayden Royster is Staff Writer and Steven Boyd Saum is Executive Director of Strategic Communications & Content at Saint Mary's. Write them.